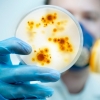
美 미시간서 치사율 35% ‘한타바이러스’ 첫 사례 보고

-
![[달콤한 사이언스] 역사속 대제국들 멸망의 과학적 원리 찾았다](https://img.seoul.co.kr/img/upload/2021/10/12/SSI_20211012130208_S.jpg)
[달콤한 사이언스] 역사속 대제국들 멸망의 과학적 원리 찾았다
2021-10-12 서울신문 -
![[여기는 중국] 대형 온라인 쇼핑몰서 주문한 택배에 살아있는 생쥐가…](https://imgnn.seoul.co.kr/img/upload/2021/09/18/SSI_20210918155113_S.jpeg)
[여기는 중국] 대형 온라인 쇼핑몰서 주문한 택배에 살아있는 생쥐가…
2021-09-18 나우뉴스 -

고지방식 신체시계 파괴해 비만 유발
2021-09-09 서울신문 -

항암제 위치 추적하고 작용속도 조절도 되는 기술 개발
2021-09-07 서울신문 -

고지혈증 치료제로 난치성 암 치료한다?!
2021-08-24 서울신문 -
![[달콤한 사이언스] 나이들면서 ‘깜박깜박’ 건망증 치료법 찾았다](https://img.seoul.co.kr/img/upload/2021/08/23/SSI_20210823152147_S.jpg)
[달콤한 사이언스] 나이들면서 ‘깜박깜박’ 건망증 치료법 찾았다
2021-08-23 서울신문 -

영화 속의 호빗 닮은꼴 생명체 등장… 공룡 다음 포유류 시대 시작된 흔적
2021-08-19 서울신문 -

무궁화·애기땅빈대 활용한 기능성 제품 개발
2021-08-12 서울신문 -
![[과학계는 지금] 엄마 분변 이식해 신생아 당뇨 예방](https://img.seoul.co.kr/img/upload/2021/07/21/SSI_20210721175318_S.jpg)
[과학계는 지금] 엄마 분변 이식해 신생아 당뇨 예방
2021-07-22 서울신문 -
![[달콤한 사이언스] 열심히 외웠는데 기억 안나는 이유, 알고보니...](https://img.seoul.co.kr/img/upload/2021/07/13/SSI_20210713125326_S.jpg)
[달콤한 사이언스] 열심히 외웠는데 기억 안나는 이유, 알고보니...
2021-07-13 서울신문 -

메타버스, 가상현실 적용 가능한 인공감각 개발됐다
2021-07-12 서울신문 -

인체무해하고 수명 긴 뇌 삽입형 기기 코팅기술 나왔다
2021-07-11 서울신문 -

이종장기이식 수술 성공 사전에 예측할 수 있는 기술 나왔다
2021-07-08 서울신문 -

뇌 속 치매원인물질 스스로 잡아먹고 분해시키는 방법 찾았다
2021-06-27 서울신문 -
![[유용하 기자의 사이언스 톡] 생쥐를 빼고 과학연구를 말할 수 없는 이유](https://img.seoul.co.kr/img/upload/2021/06/16/SSI_20210616213717_S.jpg)
[유용하 기자의 사이언스 톡] 생쥐를 빼고 과학연구를 말할 수 없는 이유
2021-06-17 서울신문 -

침으로 간 자극하니 우울증 치료되네
2021-06-11 서울신문 -

항암치료 대표 부작용, 심독성 심장질환 차단법 찾았다
2021-06-10 서울신문 -

침으로 우울증 개선한다…우울증과 간기능 연관성 확인
2021-06-10 서울신문 -
美 미시간서 치사율 35% ‘한타바이러스’ 첫 사례 보고
2021-06-09 나우뉴스 -

코에 칙~칙~ 뿌리면… 코로나 바이러스 뚝?
2021-06-07 서울신문 -
![[달콤한 사이언스] 코에 뿌리는 코로나19 백신, 치료제 나오나](https://img.seoul.co.kr/img/upload/2021/06/06/SSI_20210606144441_S.jpg)
[달콤한 사이언스] 코에 뿌리는 코로나19 백신, 치료제 나오나
2021-06-06 서울신문 -
![[유용하 기자의 사이언스 톡] 엄마가 아이 구하려 위험 무릅쓰는 까닭은](https://img.seoul.co.kr/img/upload/2021/06/03/SSI_20210603005946_S.jpg)
[유용하 기자의 사이언스 톡] 엄마가 아이 구하려 위험 무릅쓰는 까닭은
2021-06-03 서울신문 -

파국 알리는 벨소리… 무대 위 더 실감나네
2021-06-01 서울신문 -
![[리뷰] 휴대전화 울릴 때마다…알아도 재미있고 무대라 더 쫄깃한 ‘완벽한 타인’](https://img.seoul.co.kr/img/upload/2021/05/31/SSI_20210531153030_S.jpg)
[리뷰] 휴대전화 울릴 때마다…알아도 재미있고 무대라 더 쫄깃한 ‘완벽한 타인’
2021-05-31 서울신문 -
[사이언스 브런치] 슈퍼맨처럼 ‘빠르고 강하게’ 만드는 유전자 발견했다
2021-05-30 서울신문 -

폐이식 외에 답 없는 특발성 폐섬유화증 원인 찾아냈다
2021-05-27 서울신문 -

‘조류독감 식별사’ 족제비, ‘포르말린 경보기’ 미생물
2021-05-27 서울신문 -
![[달콤한 사이언스] 암세포 쉽게 죽지 않고 끝없이 증식되는 이유 밝혀졌다](https://img.seoul.co.kr/img/upload/2020/01/09/SSI_20200109151559_S.jpg)
[달콤한 사이언스] 암세포 쉽게 죽지 않고 끝없이 증식되는 이유 밝혀졌다
2021-05-20 서울신문 -
![[달콤한 사이언스]자폐증 치료제 복용 아동, 소아비만 되는 이유 밝혀냈다](https://img.seoul.co.kr/img/upload/2021/05/17/SSI_20210517141236_S.png)
[달콤한 사이언스]자폐증 치료제 복용 아동, 소아비만 되는 이유 밝혀냈다
2021-05-17 서울신문 -
![[달콤한 사이언스] 가공식품 속 식용색소가 대장염, 알레르기 일으킨다](https://img.seoul.co.kr/img/upload/2021/05/13/SSI_20210513154001_S.jpg)
[달콤한 사이언스] 가공식품 속 식용색소가 대장염, 알레르기 일으킨다
2021-05-13 서울신문



![[사이언스 브런치] 슈퍼맨처럼 ‘빠르고 강하게’ 만드는 유전자 발견했다](https://img.seoul.co.kr/img/upload/2021/05/28/SSI_20210528172316_S.jfif)